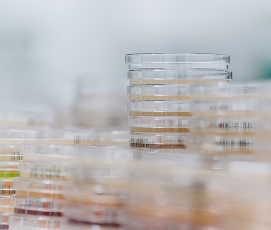
Petrischalen

Klarheit über die Qualität Ihres Wassers
Professionelle Analytik und umfassendes Hygiene-Monitoring – zuverlässig, gesetzeskonform und praxisorientiert. Wir prüfen Ihr Wasser im akkreditierten Labor, um Risiken frühzeitig zu erkennen und höchste Qualitätsstandards zu gewährleisten.
Wir analysieren Ihr Wasser ...
mikrobiologisch
chemisch
sensorisch
individuell
Fachgerechte Probenahme vor Ort durch geschultes Personal, sicheren Transport und Analyse in unserem akkreditierten Labor – gemäß den aktuellen Vorgaben der Trinkwasserverordnung (TrinkwV) und anderer relevanter Normen.
Zu unserem Analysespektrum gehören u.a. die folgenden Parameter:
- Mikrobiologische Untersuchungen
- Legionellen
- Escherichia coli, Coliforme Keime, Enterokokken
- Gesamtkeimzahlen bei 22°C und 37°C
- Chemische Untersuchungen
- Schwermetalle
- Nitrat
- pH-Wert
- Leitfähigkeit
- Sensorische Untersuchungen
- Geruch (qualitativ)
- Geschmack (qualitativ)
Probenahmepläne, Probenahmestellen oder gesonderte Analyseparameter stimmen wir im Bedarfsfall direkt mit Ihnen ab und beraten Sie gerne.
Probenahme, Analytik und Beratung

Warum regelmäßige Analysen?
Die Trinkwasserverordnung (TrinkwV) schreibt klare Grenzwerte für Bakterien und chemische Parameter vor – seit Juni 2023 mit strengeren Vorgaben für Legionellen und Schwermetalle. Regelmäßige Kontrollen schützen nicht nur Ihre Gesundheit, sondern sichern auch den rechtskonformen Betrieb Ihrer Anlagen.
Jetzt unverbindlich beraten lassen
Wir freuen uns darauf, Sie kennenzulernen.
Gemeinsam finden wir die für Sie passende Lösung, maßgeschneidert auf Ihre Bedürfnisse.


Über uns
Labor Kneißler steht seit über 30 Jahren für sichere Lebensmittel. Unser breites Leistungsspektrum umfasst nicht nur die Probenahme und Laboranalysen, sondern auch fachkundige Beratung, effektives Krisenmanagement, themenspezifische Audits und vieles mehr.